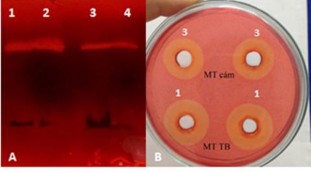
Hình 3 8 Zymogram A và vòng thủy phân B trên môi trường cám 1 và môi trường 2

và peptone là 2 nguồn nitơ tốt nhất cho quá trình sinh cellulase của B. alcalophilus
S39 và B. amyloliquefaciens C2 [112].
Bột đậu tương là một thành phần của môi trường M6. Bột đậu tương chứa 57.4% protein và 32.2% tinh bột (Akingbala, Oguntimenin et al, 1995).Kết quả trên Hình 3.6 C cho thấy với nồng độ 1.5% bột đậu tương trong môi trường thu được CMCase có hoạt tính cao nhất.
Dựa trên kết quả các khảo sát về nguồn dinh dưỡng Nitơ, nguồn Cacbon và hàm lượng bột đậu tương trong môi trường M6 (Hình 3.6) cho thấy tinh bột, casein và bột đậu tương có tác động mạnh tới quá trình sinh CMCase của chủng G4. Môi trường cho quá trình sinh CMCase được tối ưu hóa sử dụng phương pháp đáp ứng bề mặt.
Kết quả phân tích hồi qui Bảng 3.7 cho thấy mô hình có ý nghĩa (p<0.0001), 3 yếu tố Tinh bột, Casein và Bột đậu tương đều có ảnh hưởng lớn đến hoạt độ CMCase (p<0.05).
Giá trị “Lack of Fit”, (sự không tương thích của mô hình) mà chương trình tính toán và đưa ra p = 0,0787. Điều này có nghĩa, sự không phù hợp của mô hình ở đây là không có nghĩa. Khẳng định mô hình đưa ra có nghĩa.
Hệ số tương quan bội R2 = 0,9233 thể hiện sự lệch giá trị thực so với mô
hình là rất nhỏ chỉ có 7,67%. Trong mô hình này, giá trị R2 = 0,9233 > 0.75. Có thể kết luận rằng tính tương thích của mô hình là khá cao.
Hoạt độ CMCase được biểu diễn bằng mô hình bậc hai như sau:
CMCase = 4,44 + 0,47A + 1,21B + 0,75C + 0,14AB – 0,11AC – 0,32BC – 0,62A2– 0,24B2 - 0,45C2
Bảng 3.7 Phân tích hồi quy (ANOVA) kết quả thí nghiệm
Tổng bình phương | Bậc tự do | Trung bình bình phương | Giá trị F | Giá trị Prob > F | |
Mô hình | 28.189 | 9 | 3.132 | 21.3441 | < 0.0001 |
A (Tinh bột) | 2.694 | 1 | 2.694 | 18.357 | 0.0016 |
B (Casein) | 14.071 | 1 | 14.071 | 95.886 | < 0.0001 |
C(Bột đậu tương) | 5.566 | 1 | 5.566 | 37.929 | 0.0001 |
AB | 0.060 | 1 | 0.060 | 0.407 | 0.5377 |
AC | 0.050 | 1 | 0.050 | 0.342 | 0.5716 |
BC | 0.613 | 1 | 0.613 | 4.176 | 0.0682 |
Có thể bạn quan tâm!
-
Khảo Sát Khả Năng Thủy Phân Rơm Sử Dụng Cellulase Thu Nhận Từ Vi Khuẩn -
Phương Pháp Xác Định Lượng Đường Trong Mẫu Thủy Phân Bằng Sắc Ký Lỏng Cao Áp (Hplc- High Performance Liquid Chromatography) -
Đặc Điểm Hình Thái, Sinh Lý Của 11 Chủng Vi Khuẩn Tuyển Chọn -
Ảnh Hưởng Của Môi Trường Nuôi Cấy Tới Khả Năng Sinh Enzym -
Xác Định Đặc Tính Di Truyền Và Các Gen Mã Hóa Enzym Thủy Phân Cellulose Của Chủng C. Cellulans Mp1 -
Ảnh Hưởng Của Tiền Xử Lý Cơ Chất Tới Hiệu Suất Đường Hóa
Xem toàn bộ 138 trang tài liệu này.
1.222 | 1 | 1.222 | 8.329 | 0.0162 | |
B2 | 0.885 | 1 | 0.885 | 6.029 | 0.0339 |
C2 | 2.862 | 1 | 2.862 | 19.502 | 0.0013 |
Residual | 1.467 | 10 | 0.147 | ||
Lack of Fit | 1.171 | 5 | 0.234 | 3.957 | 0.0787 |
Pure Error | 0.296 | 5 | 0.059 | ||
Cor Total | 29.656 | 19 |
A2

Hình 3.7 Bề mặt đáp ứng của quá trình sinh tổng hợp CMCase từ Bacillus G4 cho thấy sự tương tác giữa (a) Hàm lượng bột đậu tương và tinh bột . (b) Hàm lượng Casein và Tinh bột. (c) Hàm lượng bột đậu tương và casein.
Kết quả tối ưu cho thấy hoạt tính CMCase cao nhất đạt được là 5,63 U/ml ở nồng độ casein 19,92g/l, nồng độ bột đậu tương 15,9 g/l và nồng độ tinh bột 19,52 g/l. Tại các giá trị tối ưu hoạt tính enzym tăng lên 1,68 lần so với trước tối ưu. Kết quả xác định hoạt độ FPU của dịch enzym thô sau tối ưu có hoạt độ đạt được là 0,113 ± 0,005 U/ml. Sự tăng hoạt độ CMCase trên môi trường sau tối ưu đã được kiểm chứng bằng vòng khuyếch tan đĩa thạch và zymogram (Hình 3.8).
Hình 3.8 Zymogram (A) và vòng thủy phân (B) trên môi trường cám (1) và môi trường tinh bột (3)
Trên Hình 3.9 là động thái sinh tổng hợp CMCase của B. subtilis G4 trên môi trường trước tối ưu và sau tối ưu cho thấy sự tăng hoạt độ CMCase rõ rệt trên môi trường sau tối ưu (Hình 3.9A). Kết quả xác định số lượng vi sinh vật cũng cho thấy sự gia tăng mật độ tế bào lên gần 2 cơ số log là một trng những nguyên nhân dẫn đến sự gia tăng hoạt độ CMCase trên môi trường sau tối ưu

Hình 3.9. Kết quả xác định hoạt độ CMCase và mật độ tế bào trên môi trườngtrước và sau tối ưu
3.3.3. Thu nhận cellulase kỹ thuật từ B. subtilis G4 và xác định đặc tính của chế phẩm
3.3.3.1. Thu nhận chế phẩm cellulase kỹ thuật từ B. subtilis G4
Thu dịch enzym bằng ly tâm dịch nuôi cấy 6000 vòng/phút trong 10 phút ở 4ºC. Kết tủa enzym bằng ammonium sulfate nồng độ 60% -80% bão hòa (Bảng 3.8) và acetone 60% -80% (Bảng 3.9).
Bảng 3.8 Kết tủa cellulase bằng ammonium sulfate bão hòa
Hoạt tính tổng (U/ml) | Tổng Protein (mg/ml) | Hoạt độ riêng (U/mg) | Độ tinh sạch | Hiệu suất thu hồi (%) |
0,53 | 1,16 | 0,15 | 5,63 | 25,60 | |
60 | 1,04 | 1,61 | 0,65 | 8,13 | 50,24 |
70 | 1,19 | 1,76 | 0,67 | 8,38 | 57,48 |
80 | 1,24 | 1,80 | 0,71 | 8,87 | 59,90 |
Enzyme thô | 2,070,01 | 25,300,36 | 0,0820,001 | 1 | 100 |
50
Cả amoni sunfat và aceton đều kết tủa enzym đạt hiệu suất thu hồi cao nhất ở nồng độ dung môi 80%. Aceton là dung môi được lựa chọn để kết tủa enzym thô thu nhận từ Bacillus G4 do có hiệu suất thu hồi cao hơn. Trong nghiên cứu này khi sử dụng aceton làm tác nhân kết tủa cellulase đạt hiệu suất thu hồi 83,57% và độ tinh sạch cao gấp 4,38 lần so với enzym thô trong khi đó với tác nhân là ammonium sunfate 80% thì hiệu suất thu hồi chỉ đạt 59,9%.
Bảng 3.9 Kết tủa cellulase bằng acetone
Hoạt tính tổng (UI/ml) | Tổng Protein (mg/ml) | Hoạt độ riêng (UI/mg) | Độ tinh sạch | Hiệu suất thu hồi(%) | |
50 | 0,65 | 2,35 | 0,29 | 3,63 | 31,40 |
60 | 1,32 | 4,16 | 0,32 | 4,0 | 63,77 |
70 | 1,56 | 4,60 | 0,34 | 4,25 | 75,36 |
80 | 1,73 | 4,90 | 0,35 | 4,38 | 83,57 |
Enzyme thô | 2,070,01 | 25,300,36 | 0,0820,001 | 1 | 100 |
Kết quả này cũng tương tự với các nghiên cứu trước đây của Ekundayo và cộng sự (2012) khi hiệu suất thu hồi cao nhất tại aceton 80% [74].
Enzym sau khi kết tủa bằng aceton 80% được sử dụng để nghiên cứu một số đặc tính của CMCase như nhiệt độ tối ưu, pH tối ưu, tính bền nhiệt, bền pH.
3.3.3.2. Đặc tính của chế phẩm cellulase từ vi khuẩn B. subtilis G4
Nhiệt độ tối ưu của enzym là nhiệt độ mà tại đó hoạt độ enzym đạt được cao nhất. Tiến hành xác định hoạt độ ở các nhiệt độ từ 30°C đến 90°C, kết quả thể hiện ở Hình 3.10.

Hình 3.10 Nhiệt độ tối ưu của CMCase thu nhận từ G4
Kết quả ảnh hưởng của nhiệt độ tới hoạt độ enzym cho thấy cellulase thu nhận từ G4 có hoạt độ cao nhất ở 60oC. Hoạt độ CMCase ở 70 oC chỉ giảm khoảng 10% tuy nhiên ở 80 oC giảm mạnh và mất hoàn toàn hoạt tính ở 90 oC. Nhiệt độ tối ưu của một số chủng Bacillus khác như CH4 và RH trong nghiên cứu của Mawada và cộng sư (2000) là 65°C và 70°C [113].
150
100
50
0
30 40 50 60 70 80
Nhiệt độ (°C)
Hoạt độ CMCase còn lại
(%)
Nghiên cứu độ bền của enzym bởi nhiệt độ chúng tôi ủ enzym ở các nhiệt độ khác nhau trong 2 giờ. Kết quả xác định hoạt độ còn lại của enzym so với ban đầu như hình 3.11.
Hình 3.11 Độ bền của enzym bởi nhiệt độ
Kết quả hình trên cho thấy cellulase từ vi khuẩn G4 có hoạt tính ổn định khi bảo quản dưới 50ºC, với nhiệt độ 60ºC trở lên hoạt tính enzym giảm dần và giảm nhanh đến mất hoạt tính khi giữ ở nhiệt độ 70ºC trở lên, kết quả này cũng tương tự khi nghiên cứu độ bền bởi nhiệt độ của cellulase từ các Bacillus [99]. Tuy nhiên khi so sánh với một số chủng Bacillus có khả năng chịu nhiệt thì độ bền nhiệt của G4 kém hơn. Như các chủng Bacillus trong nghiên cứu của Ekundayo và cộng sự thì các chủng này có khả năng chịu được nhiệt độ đến 70ºC [74].
Xác định giá trị pH tối ưu của enzym thu nhận từ vi khuẩn G4 chúng tôi tiến hành xác định hoạt độ enzym ở các pH khác nhau tương ứng pH - 3, 4, 5, 6, 7, 8, 9 và pH 10 (sử dụng các dung dịch đệm tương ứng). Để kiểm tra độ bền của enzym bởi pH chúng tôi cho enzym vào các dung dịch đệm có giá trị pH khác nhau và ủ
trong 2 giờ, sau đó xác định hoạt tính còn lại của enzym kết quả thu được ở Hình
3.12 và hình 3.13

120
100
80
60
40
20
0
3 4 5 6 7 8 9 10
pH
Hoạt độ CMCase còn lại
(%)
Hình 3.12. pH tối ưu cho hoạt dộ CMCase của chế phẩm cellulase từ B. subtilis G4
Hình 3.13. Độ bền pH của chế phẩm cellulase từ Bacillus G4
Các kết quả trên cho thấy cellulase thu nhận từ G4 có hoạt tính cao nhất tại pH 7, tuy nhiên khoảng pH hoạt động tương đối rộng từ pH 4 tới pH 8, hoạt độ tại 4 và 8 đạt hơn 80% giá trị tối ưu.Hoạt độ giảm nhiều nhất tại pH 3 chỉ bằng 37% trong khi tại pH 9 vẫn đạt tới 67% giá trị tối ưu tại pH7.
Về độ bền của CMCase bởi pH cho thấy enzym bền với các trị pH từ 5-7 với các giá trị pH nhỏ hơn 5 hoạt tính enzym giảm nhanh, với các giá trị pH 8, 9 hoạt tính giảm chậm hơn. So sánh với một số nghiên cứu về giá trị pH hoạt động của các Bacillus khác cũng cho kết quả tương tự [107][74]. Như vậy chế phẩm cellulase từ
B. subtilis G4 hoạt động tốt ở vùng pH từ 5-8.
3.3.4. Khảo sát khả năng thủy phân của cellulase từ vi khuẩn G4 đối với các vật liệu giàu cellulose.
Khảo sát khả năng thủy phân lignocellulose của cellulase từ vi khuẩn G4 chúng tôi sử dụng dịch enzym thô để thủy phân các cơ chất bã mía, rơm,và các cơ chất đã tiền xử lý bằng NaOH.
Điều kiện thủy phân là các điều kiện tối ưu cho hoạt động của enzym: Nhiệt độ 60ºC, pH 7,0, nồng độ cơ chất 1% ml, nồng độ enzym 4,5U/ml. Xác định hàm lượng đường khử tạo thành sau 24 giờ thủy phân. Kết quả thu được ở Bảng 3.10
Bảng 3.10 Kết quả thủy phân lignocelluloses sử dụng enzym từ vi khuẩn G4
Hàm lượng đường khử tạo thành | |
Rơm | 1,12±0,13 |
Bã mía | 1,09±0,27 |
Rơm đã tiền xử lý bằng NaOH | 1,78±0,21 |
Bã mĩa đã tiền xử lý bằng NaOH | 1,49±0,15 |
Kết quả bảng trên cho thấy hàm lượng đường khử tạo thành sau thủy phân không cao dù sử dụng nồng độ enzym lớn trong dung dịch thủy phân (446U/g) hiệu quả quá trình thủy phân thấp, hiệu suất ước tính chỉ đạt từ 15%-30%.
Để biết được thành phần của dịch sau thủy phân chúng tôi tiếp tục phân tích hàm lượng glucose, xylose của dịch sau thủy phân, kết quả xác định thể hiện ở hình 3.14

Hình 3.14: Kết quả phân tích sản phẩm thủy phân bằng HPLC
Kết quả kiểm tra sản phẩm thủy phân bằng HPLC cho thấy không có sự tạo thành các sản phẩm đường của quá trình thủy phân như glucose, xylose điều này cho thấy hàm lượng đường khử đo được bằng DNS chủ yếu là các gốc khử của oligosacharid. Có thể thấy được hệ cellulase của vi khuẩn G4 chủ yếu là endoglucanse, không có hoặc có rất ít các enzym khác trong hệ enzym thủy phân lignocellulose. Vì vậy enzym G4 chỉ phù hợp với quá trình thủy phân cellulose tinh khiết như CMC hoặc là nguồn enzym bổ sung để thiết kế hệ enzym Cellulosome.
3.4. Nghiên cứu cellulase từ vi khuẩn Cellulosimicrobium MP1
3.4.1. Nghiên cứu lựa chọn môi trường và điều kiện sinh tổng hợp cellulase từ MP1
3.4.1.1. Lựa chọn môi trường sinh tổng hợp cellulase
Vi khuẩn MP1 được nuôi cấy trên các môi trường LB, M1 M2 và M6 trong thời gian 48 giờ ở 37C, tốc độ lắc 100 vòng/phút, sau đó xác đinh hoạt tính CMCase trên các môi trường tương ứng, kết quả thu được ở bảng sau






